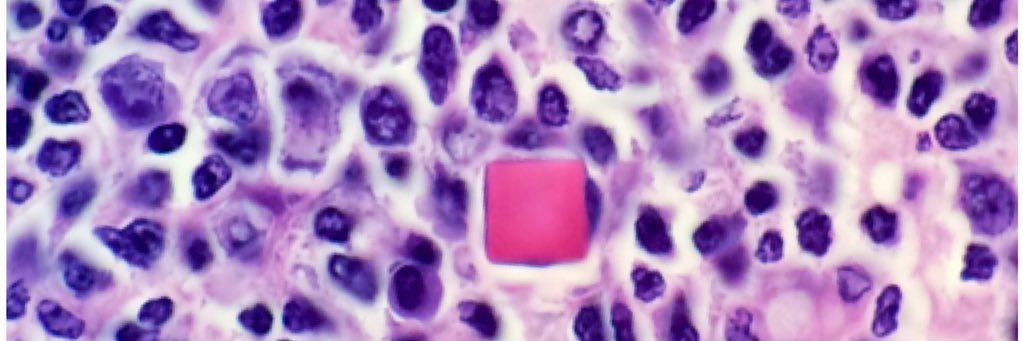
Forest Huls, MD banner

My 2024 pumpkin (or Munchkin?)
Whether you’ll be trick-or-treating with your adorably costumed kiddos, or carving an icon of existential terror into a fruit that will immediately rot on your front porch, or both…Happy Halloween!!!
#pathology #pumpkincarving



English